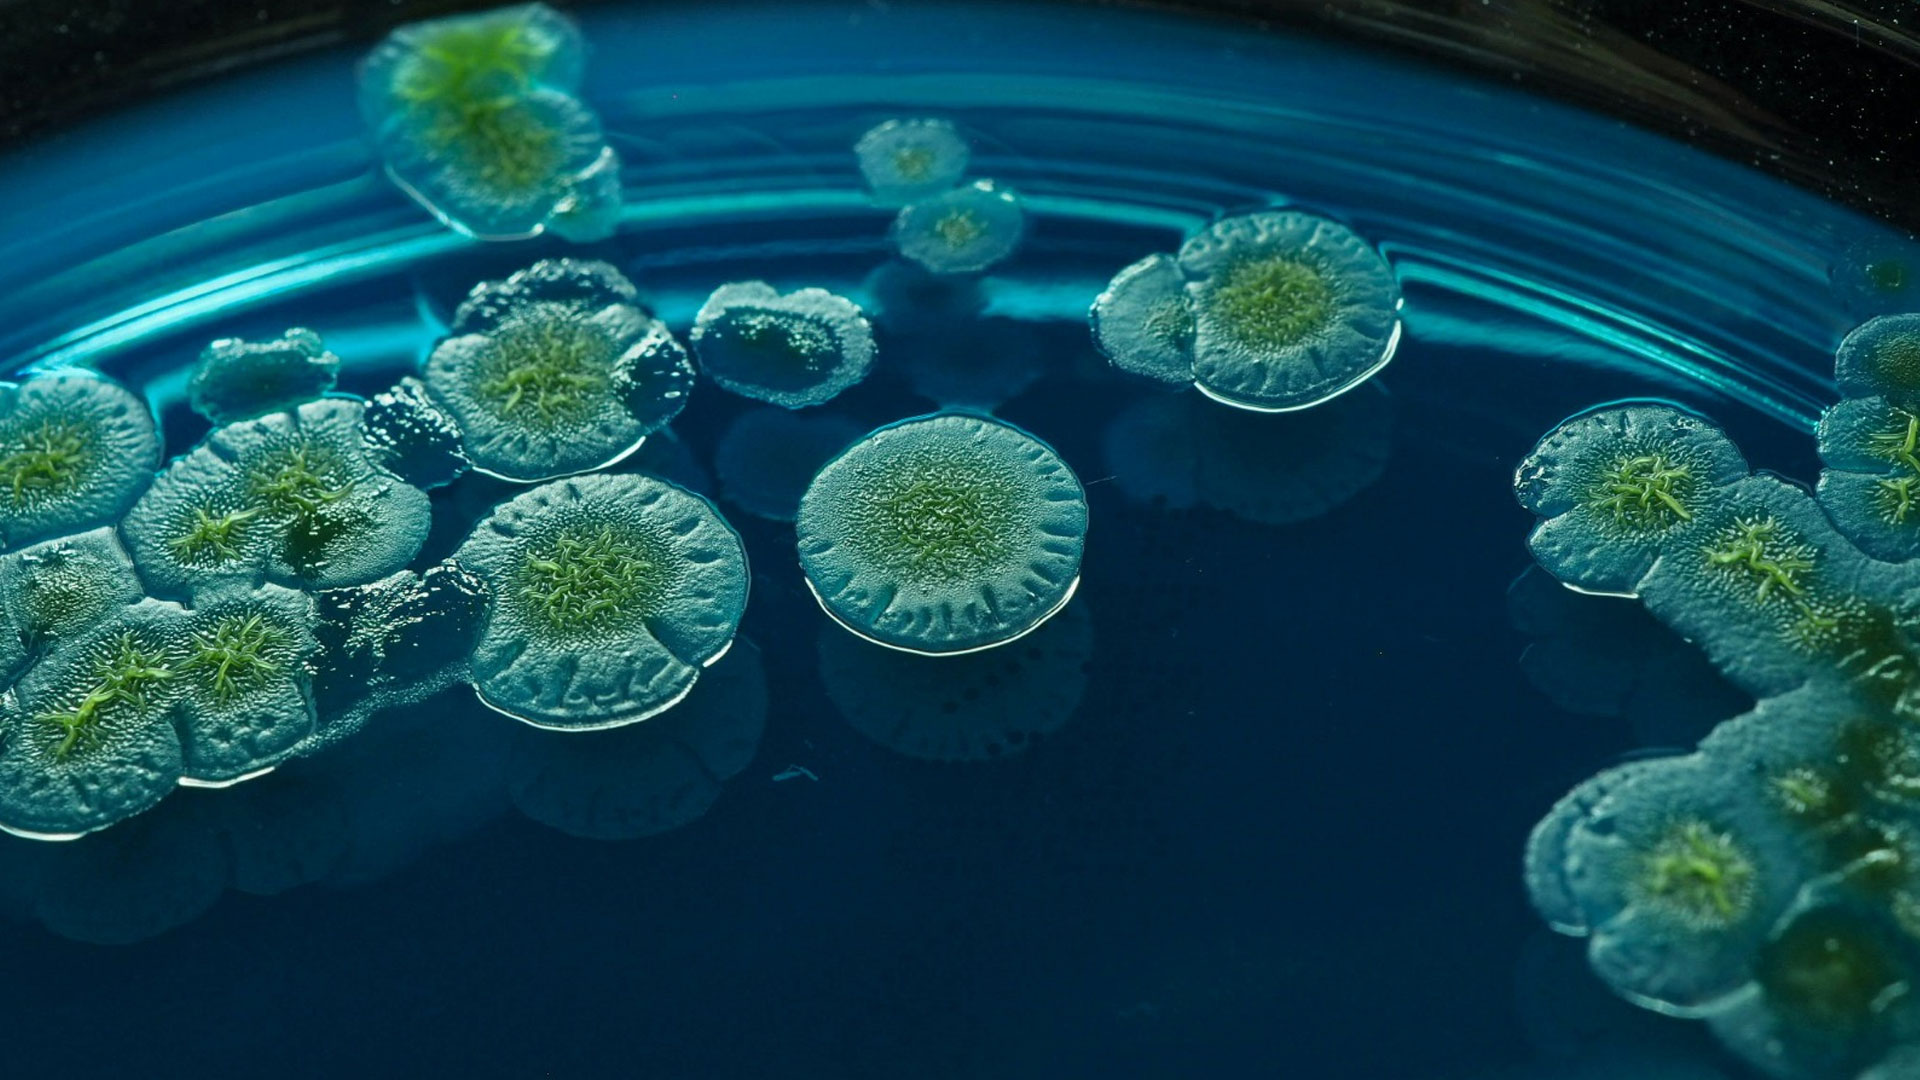
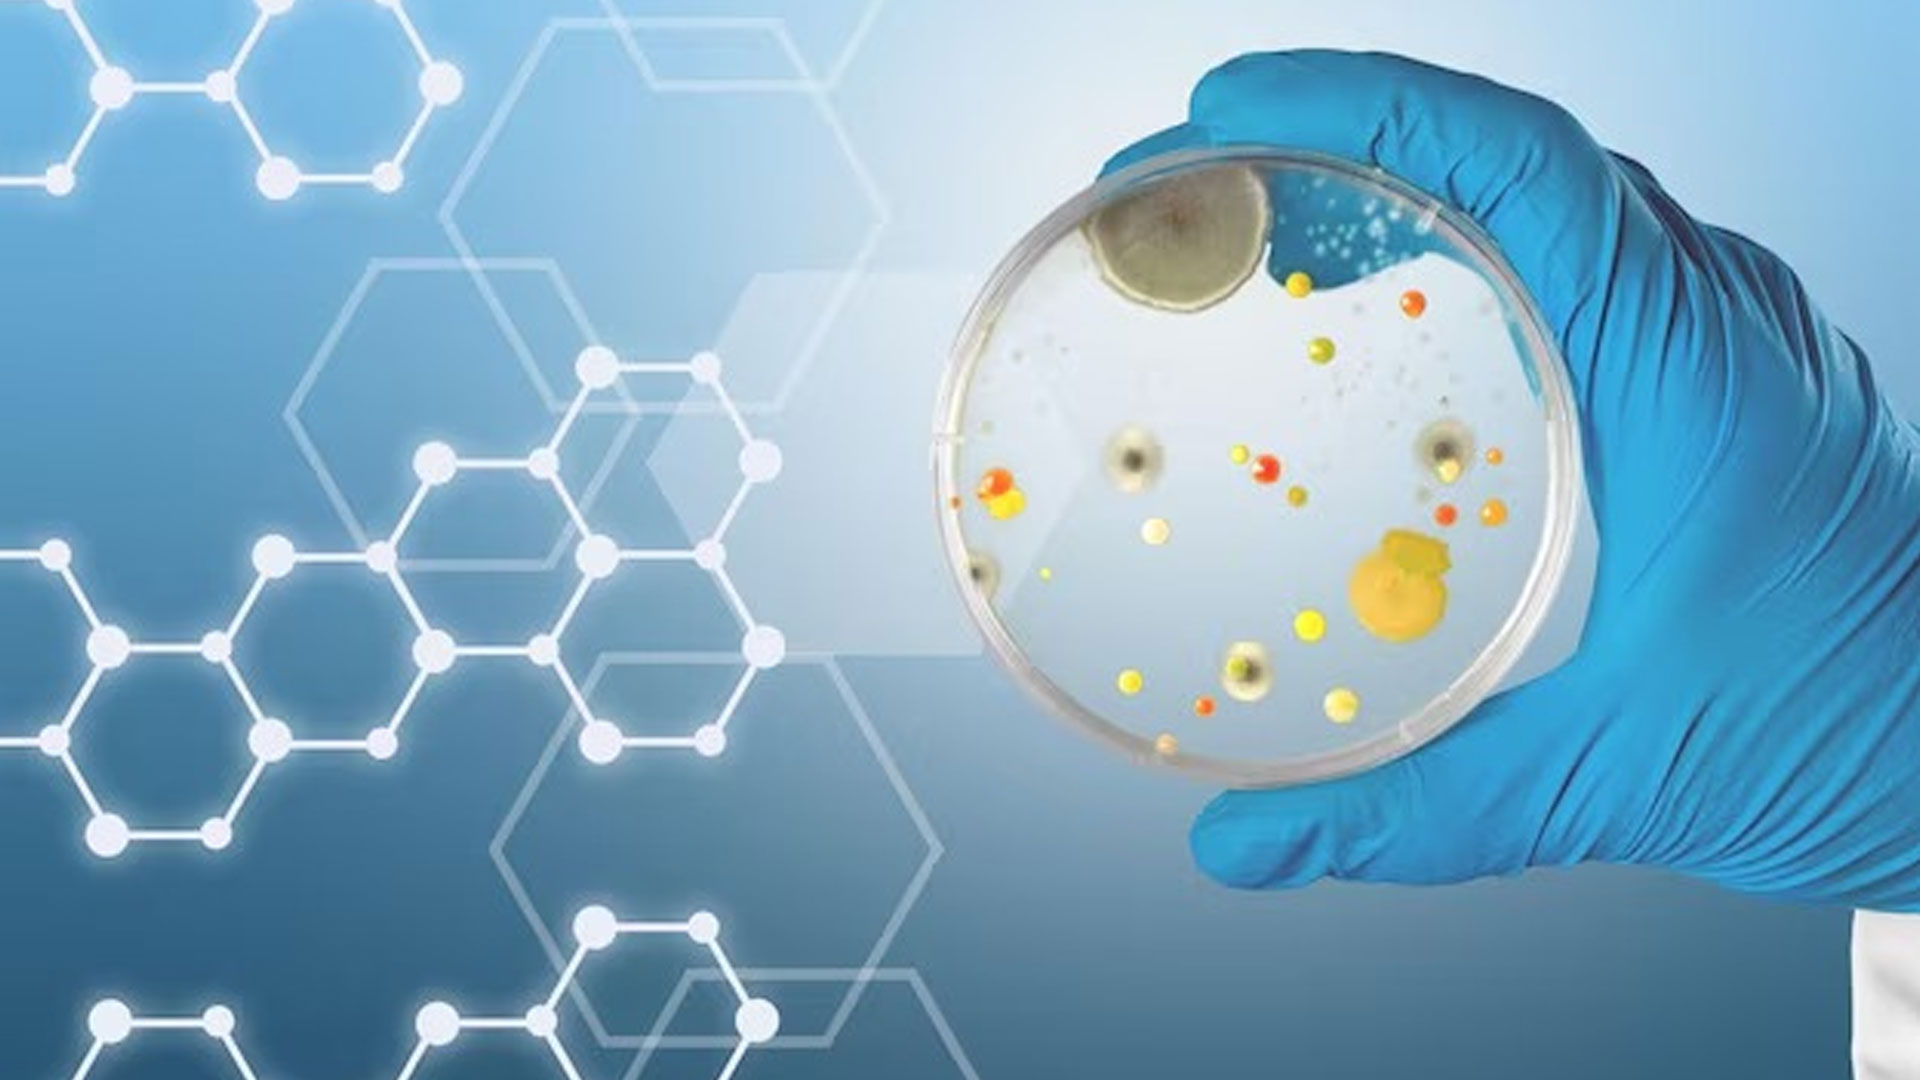

Welcome To Aphodis
All Solutions, One Source
Empowering industries with premium laboratory chemicals, microbiology media, and top-tier lab equipment.
Read More
Comprehensive microbiology and chemical laboratory consumables
Find Out More
High-yield media for molecular laboratory
Find Out More